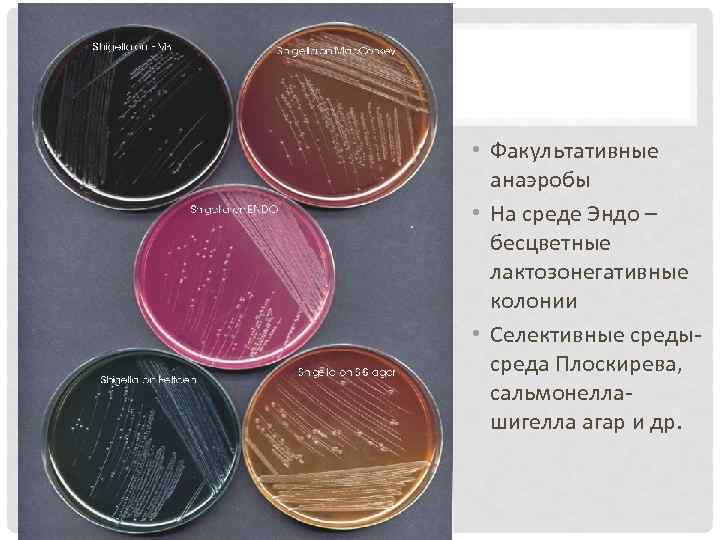
• Факультативные анаэробы • На среде Эндо – бесцветные лактозонегативные колонии • Селективные
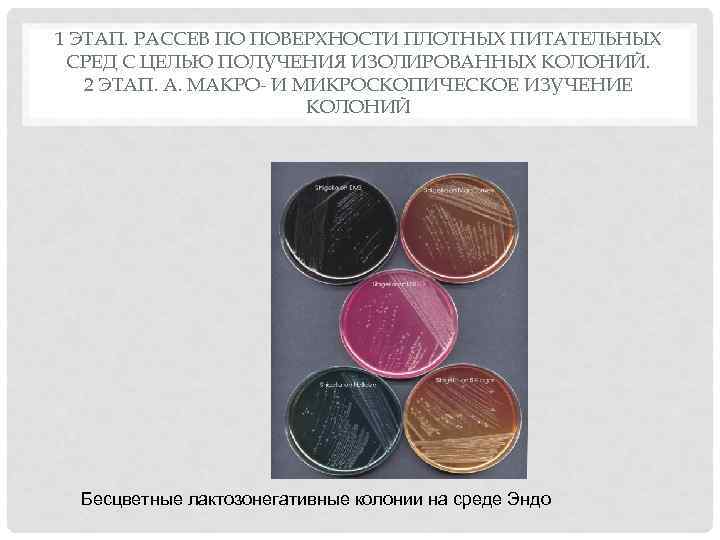
1 ЭТАП. РАССЕВ ПО ПОВЕРХНОСТИ ПЛОТНЫХ ПИТАТЕЛЬНЫХ СРЕД С ЦЕЛЬЮ ПОЛУЧЕНИЯ ИЗОЛИРОВАННЫХ КОЛОНИЙ. 2

shigella.ppt
- Количество слайдов: 28

ВОЗБУДИТЕЛИ ДИЗЕНТЕРИИ Enterobacteriaceae • Род Shigella • Виды: Shigella dysenteriae, • S. flexneri, • S. boydii, • S. sonnei • Семейство •

МОРФОЛОГИЯ Мелкие грамотрицательные палочки с закругленными концами, неподвижны

ШИГЕЛЛЫ, РАСПОЛОЖЕННЫЕ ВНУТРИКЛЕТОЧНО
• Факультативные анаэробы • На среде Эндо – бесцветные лактозонегативные колонии • Селективные среды- среда Плоскирева, сальмонеллашигелла агар и др.

• Биохимически малоактивны, расщепляют отдельные углеводы только до кислоты; чувствительны к дезинфектантам Для дифференциации до рода Shigella основные признаки: q Неподвижность q Ферментация глюкозы до кислоты (исключение Sh. flexneri серовар 6) q Отсутствие ферментации лактозы q Отсутствие продукции сероводорода

АНТИГЕНЫ • О-антиген - термостабильный, ЛПС наружной мембраны • К-антиген – капсульный антиген= поверхностные полисахариды, термолабильный По О-антигену выделяют серогруппы и серотипы

ФАКТОРЫ ПАТОГЕННОСТИ • Фимбрии и белки наружной мембраны – факторы адгезии; • Инъекционные токсины (нарушают цитоскелет) • Факторы апоптоза • Эндотоксин (ЛПС); • Шига и шигаподобные токсины Микроорганизмы Обозначение гена Токсин Старое название Shigella dysenteriae, type I и другие шигеллы stx Shiga toxin (Stx) Shiga toxin Шигеллы, сальмонелы и диареегенные эшерихии stx 1 Shiga toxin 1 (Stx 1) Шигаподобный токсин 1, веротоксин 1 Шигеллы, сальмонелы и диареегенные эшерихии stx 2 Shiga toxin 2 (Stx 2) Shiga-like toxin II, Verotoxin 2 • S. flexneri, S. boydii, и S. sonnei способны продуцировать LT-энтеротоксин

ШИГА- ТОКСИНЫ v Термолабильные токсины с типичной АВ – структурой v Субъединица А и пять субъединиц В. Пентамер В взаимодействует с рецепторами на поверхности клетки, субъединица А в цитоплазме распадается на А 1 и А 2; А 1 взаимодействует с большой субъединицей рибосомы, что приводит к прекращению синтеза белка и гибели клетки v Может взаимодействовать с рецепторами энтероцитов, макрофагов и нервных клеток v Обладает цитотоксическим, нейротоксическим и энтеротоксическим эффектами v Шига-токсин может вызывать гемолитический уремический синдром с развитием почечной недостаточности v Шигаподобные токсины отличаются по антигенным свойствам, имеют сходный механизм действия, менее токсичны


• Информация о факторах патогенности хранится в гигантской плазмиде • Продукция LT- энтеротоксина находится под контролем Ent – плазмиды • R – плазмиды обеспечивают устойчивость к антибиотикам

МЕХАНИЗМ ВЗАИМОДЕЙСТВИЯ SHIGELLA С ЭПИТЕЛИАЛЬНЫМИ КЛЕТКАМИ ТОЛСТОГО КИШЕЧНИКА 1) Shigella стимулирует энтероциты к продукции сигнальных молекул, привлекающих дендритные клетки, проникает в них и использует для транспорта серез слизистую 2) Shigella высвобождается из дендритных клеток, индуцируя их апоптоз. 3) Shigella использует свои инвазины для проникновения в энтероциты с базальной стороны. Инъекционные белки нарушают цитоскелет энтероцита, в результате чего бактерия поглощается и оказывается внутри эндосомы. После чего шигелла выходит в цитоплазму и размножается. 4) Shigella способны перемещаться в соседние энтероциты с помощью «пропеллера» из полимеризованного актина. 5) Когда бактерия достигает ЦПМ, актиновые филаменты проталкивают ее в соседнюю клетку.

SHIGELLA FLEXNERI ИНФИЦИРУЕТ КУЛЬТУРУ КЛЕТОК HELA Флуоресцентная окраска: клетки шигеллы (красные) перемещаются с помощью полимеризованного актина (зеленый) Электронная микрофотография Shigella, окруженная мембраной эндосомы в эпителиальной клетке

Патогенез q Распространение шигелл сопровождается развитием воспалительного процесса с изъязвлением эпителия: q Высвобождение эндотоксина при гибели шигелл сопровождается типичными биологическими эффектами (см. общую характеристику энтеробактерий) q Shigella индуцирует апоптоз клеток q. Действие Шига- и Шига-подобных экзотоксинов приводит к местной гиперсекреции и развитию диареи инвазивного типа, блокирует синтез белка

ПАТОГЕНЕЗ q. Токсины шигелл оказывают повреждающее действие на все органы и системы организма, прежде всего на ЦНС. Поражение нервной системы происходит как в результате непосредственного действия токсина на интерорецепторы сосудов нервной ткани, так и за счет сложных рефлекторных взаимодействий, возникающих в результате раздражения окончаний нервных волокон, расположенных в слизистой оболочке кишки. q. Отмечаются изменения в эндокринной, сердечно – сосудистой системе. У большинства больных с шигеллезом нарушается экскреторная функция поджелудочной железы как в острый период, так и в период ранней реконвалесценции. q. Степень вовлечения в патологический процесс почек зависит от тяжести заболевания. При среднетяжелой форме происходит токсическое поражение почек, в тяжелых случаях возможно развитие острой почечной недостаточности и гемолитико – уремического синдрома.

РЕЗИСТЕНТНОСТЬ • Возбудители дизентерии, особенно шигеллы Зонне, отличаются высокой выживаемостью во внешней среде. • В зависимости от температурно-влажностных условий они сохраняют свои биологические свойства от 3 -4 сут до 1 -2 мес, а в ряде случаев до 3 -4 мес и даже более. • При благоприятных условиях шигеллы способны к размножению в пищевых продуктах (салатах, винегретах, вареном мясе, фарше, вареной рыбе, молоке и молочных продуктах, компотах и киселях), особенно шигеллы Зонне.

ЭПИДЕМИОЛОГИЯ • Источником инфекции при дизентерии являются больные острой и хронической формой, а также бактерионосители, лица с субклинической формой инфекции, которые выделяют шигеллы во внешнюю среду с фекалиями. После перенесенного заболевания могут наблюдаться хронические бактерионосители (носительство в теченте нескольких месяцев). Наиболее контагиозны больные острыми, типично протекающими формами заболевания. • Дизентерия – антропоноз с фекально-оральным механизмом передачи • Болеют люди всех возрастов, но чаще дети первых лет жизни

ЭПИДЕМИОЛОГИЯ Ø В начале XX столетия преобладали шигеллы Григорьева-Шига. Ø Перед второй мировой войной и в послевоенные годы у больных чаще всего выделяли шигеллы Флекснера. Ø В последние 15— 20 лет в большинстве стран Европы и Америки, а также почти на всей территории Советского Союза с наибольшей частотой встречается возбудитель вида Зонне. Ø Но совсем недавно в ряде стран, например, в Гватемале, в США, вновь появилась дизентерия, вызванная шигеллами Григорьева-Шига Ø Дизентерия Зонне отличается более легким течением, преобладанием стертых форм. Характерно для нее поражение желудка и тонкого отдела кишечник. Клиническая картина скорее похожа на сальмонеллез. Ø Дизентерия Флекснера протекает обычно тяжелее и часто приводит к развитию затяжных и хронических форм. Ø Дизентерия, вызванная шигеллами Григорьева-Шига, протекает очень тяжело. Ø Существует в клинике дизентерии одна важная проблема—неполного выздоровления и развития постдизентерийных состояний. Ø После дизентерии могут надолго остаться нарушения процессов пищеварения, непереносимость отдельных пищевых продуктов, чаще всего молока, развиться дефекты моторной функции толстой кишки.

КЛИНИЧЕСКИЕ ПРОЯВЛЕНИЯ ШИГЕЛЛЕЗОВ Инфекционная доза – 100 клеток Инкубационный период 2 -3 дня Опорный симптом – эритроциты в испражнениях Заболевание начинается остро и характеризуется лихорадкой, общей интоксикацией, схваткообразными абдоминальными болями, тенезмами, учащенным стулом и диареей • Выделяют следующие формы и варианты течения инфекции: v. Острая дизентерия: колитический и гастроэнтероколитический варианты. По тяжести течения они подразделяются на легкие, среднетяжелые, тяжелые и очень тяжелые; по особенностям течения выделяют стертые, субклинические и затяжные. v. Хроническая дизентерия: рецидивирующая и непрерывная. v. Бактерионосительство шигелл: реконвалесцентное и транзиторное. Форма, вариант и тяжесть течения дизентерии зависят от путей и способов заражения, величины инфицирующей дозы шигелл, их вирулентности, уровня резистентности и иммунитета макроорганизма. • •

ЛАБОРАТОРНАЯ ДИАГНОСТИКА ШИГЕЛЛЕЗОВ Клинический материал: испражнения, ректальный мазок. Методы: 1. 2. 3. 4. Бактериологический (культуральный метод) – основной; Экспресс-методы – обнаружение антигенов шигелл: латексагглютинация, иммунофлуоресцентный прямой, РОНГА; ИФА для обнаружения токсинов Молекулярно-генетический: ПЦР Серологический методы для выявления антител применяются ограниченно с целью ретроспективной диагностики ELISA для определения Shiga токсинов в испражнениях

БАКТЕРИОЛОГИЧЕСКИЙ МЕТОД Проводят в кратчайшие сроки – «у постели больного» Предварительный этап. Посев в селенитовый бульон 1 этап: Посев клинического материала или пробы из селенитового бульона на среды Эндо, Плоскирева и др. 2 этап: Макро- и микроскопическое изучение колоний пересев лактозонегативных колоний на среды Ресселя или Клиглера. 3 этап: Идентификация по совокупности свойств: культуральных, морфологических, тинкториальных; биохимических по результатам роста на дифференциальнодиагностических средах системы API-20 E; серологическая (антигенная) идентификация в реакциях агглютинации на стекле (с поливалентной дизентерийной сывороткой и с группоспецифическими сыворотками); определение чувствительности к антибиотикам диско-диффузионным методом.

ЭТАПЫ МИКРОБИОЛОГИЧЕСКОГО ИССЛЕДОВАНИЯ Получение проб биоматериала (испражнения, ректальный мазок)

1. БАКТЕРИОЛОГИЧЕСКИЙ МЕТОД ПРЕДВАРИТЕЛЬНЫЙ ЭТАП Селенитовый бульон Среда предназначена для накопления и выделения бактерий рода Salmonella и Shigella
1 ЭТАП. РАССЕВ ПО ПОВЕРХНОСТИ ПЛОТНЫХ ПИТАТЕЛЬНЫХ СРЕД С ЦЕЛЬЮ ПОЛУЧЕНИЯ ИЗОЛИРОВАННЫХ КОЛОНИЙ. 2 ЭТАП. А. МАКРО- И МИКРОСКОПИЧЕСКОЕ ИЗУЧЕНИЕ КОЛОНИЙ Бесцветные лактозонегативные колонии на среде Эндо

2 ЭТАП. Б. ОТБОР КОЛОНИЙ ШИГЕЛЛ ПО РЕЗУЛЬТАТАМ РЕАКЦИИ АГГЛЮТИНАЦИИ НА СТЕКЛЕ Реакция агглютинации бактерий из трех лактозонегативных колоний с поливалентной дизентерийной сыороткой. Дайте интерпретацию полученным результатам и объясните дальнейшие действия.

Чистая культура на среде Клиглера: глюкоза+, лактоза- 3 ЭТАП. А. Биохимическая идентификация Б. Серотипирование Учет реакции агглютинации чистой культуры с монорецепторными адсорбированными шигеллезными сыворотками, содержащими антитела к: А. S. sonnei В. S. flexneri серотип 1 -5 С. S. flexneri серотип 6 D. Shigella dysenteriae серотип 1 E. Shigella dysenteriae серотип 2 G. Shigella dysenteriae серотип 3 -7 Вывод: Выделена чистая культура S. sonnei

3 ЭТАП. В. ЧУВСТВИТЕЛЬНОСТЬ К АНТИБИОТИКАМ

ЛЕЧЕНИЕ • Симтоматическое: пероральная (в тяжелых случаях внутривенная) регидратация • Патогенетическое: v. Антибиотикотерапия (ампициллин, триметоприм, фторхинолоны, ципрофлоксацин) v. Лечебные фаги (дизентерийный поливалентный бактериофаг) v. Инактивированная дизентерийная вакцина (содержит взвесь убитых шигелл) для лечения хронических форм инфекции v. Препараты для коррекции микрофлоры кишечника

СПЕЦИФИЧЕСКАЯ ПРОФИЛАКТИКА • Вакцина дизентерийная против шигелл Зонне липополисахаридная жидкая представляет собой раствор липополисахарида, извлеченного из культуры Shigella sonnei, очищенного ферментативными и физико - химическими методами. Консервант - фенол. Бесцветная прозрачная жидкость. • ИММУНОЛОГИЧЕСКИЕ СВОЙСТВА • Введение вакцины приводит к быстрому и интенсивному нарастанию в крови вакцинированных специфических антител, обеспечивающих через 2 -3 недели невосприимчивость к инфекции в течение 1 года.
shigella.ppt